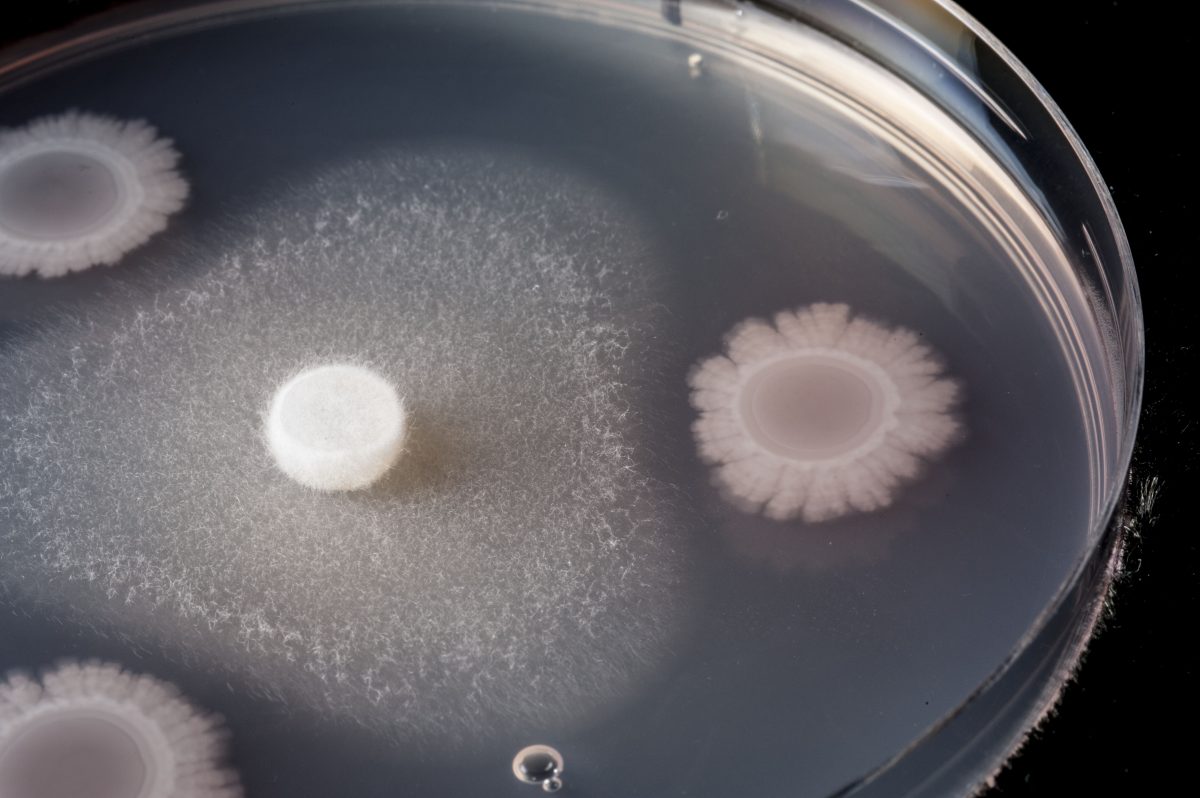

Исследование бактерий: Pseudomonas syringae в природе и науке

Раздел: Сборник идей